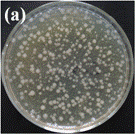

抗菌型生物活性涂层
李恺
骨修复及替换手术是在大气环境下进行,易将空气中、患者或术者体表的葡萄球菌、绿脓杆菌等病原微生物带入手术部位,从而诱发植入体相关感染。感染一旦发生,将给患者带来极大的痛苦,并将面临翻修手术。为了预防骨植入体相关感染,越来越多的研究关注于植入体的抗菌性能。除了使用抗生素骨水泥预防感染外,局部抗菌方法研究目前主要集中在植入物表面的抗菌涂层,其中加载无机抗菌剂(银、锌或铜)或相应金属离子的生物活性陶瓷涂层被较广泛的研究。
采用等离子体喷涂技术制备的钙-硅基(Ca-Si based)生物活性涂层粗糙表面易于组织细胞攀附生长,但同时也为致病细菌的黏附提供有利场所。因此,为了抑制材料表面细菌定植和生物膜形成,减少术后感染发生几率,本实验室通过在钙-硅基涂层中添加无机抗菌剂锌(Zn),制备了具有抗菌性能生物活性涂层材料(记作CSZ涂层)。
金黄色葡萄球菌(S. aureus)和大肠杆菌(E. coli)是导致植入物手术术后感染的常见菌种,它们分别属于革兰氏阳性和革兰氏阴性细菌。S. aureus的细胞壁较厚(20-80nm),但结构简单,主要由15-50层肽聚糖构成,线性的肽聚糖由小肽连接成相互交联的网状立体结构,为细胞保持外形结构。E. coli细胞壁相对较薄(10-15nm),富有弹性,呈多层结构;一般分为内外两层:外层是革兰氏阴性菌特有组分外膜,主要由脂类和多糖共价连接的脂多糖构成,内层为2-5层的肽聚糖结构。当E. coli遭遇有害物质毒性作用时,易观察到菌体固有形态和内部营养物质的变化,因此,我们选用E. coli作为实验用菌,表征CSZ涂层抗菌性能,研究其抗菌机制。

图1锌掺杂硅酸钙涂层对E. coli的抗菌效果:(a)对照Ti-6Al-4V,(b)CSZ涂层
图1显示E.coli在Ti-6Al-4V对照件和CSZ涂层表面培养24小时,再于琼脂板中培养24小时的菌落数实验结果。与Ti-6Al-4V对照相比,CSZ涂层表面的菌落数明显减少,对E. coli的抑菌率为83%,表明锌掺杂涂层具有明显的抗菌效果。
图2 E. coli在Ti-6Al-4V(a,b)、CSZ涂层(c,d)表面培养0小时和24小时的双光子共聚焦显微镜形貌


![]()

导致植入体相关性感染的主要原因是植入体表面细菌的定植和随后的细菌生物膜的附着。抑制细菌在植入体表面繁殖,可以防止生物膜的形成,减小感染发生的几率。双光子共聚焦显微镜观察(图2)显示,经24小时培养,E. coli在Ti-6Al-4V表面大量繁殖,而锌掺杂改性硅酸钙涂层表面细菌数量明显小于对照件表面。CSZ涂层表面的细菌数量在培养前后没有明显变化,表明含锌涂层可以明显抑制细菌在其表面的繁殖。




图3 E. coli在Ti-6Al-4V(a,b)和CSZ涂层(c,d)表面培养24小时的SEM形貌
E.coli在Ti-6Al-4V和CSZ涂层表面培养24小时的SEM形貌如图3所示。对照件Ti-6Al-4V表面的细菌(图3a)具有E. coli代表性的正常形貌。细菌呈现杆状,表面平滑、无损伤,如图3b所示。与CSZ涂层作用后的大肠杆菌形貌发生明显变化(图3c和d),细菌两头破裂并呈扁平状形貌特征,细菌表面褶皱。
利用TEM观察Ti-6Al-4V和CSZ涂层表面培养24小时的E. coli细胞壁和内部形貌变化,如图4所示。图4a为E. coli代表性的TEM形貌,细菌蓬松的绒毛结构是细胞壁外膜的组成部分。外膜主要由成千上万紧密堆积的脂多糖分子构成,它为菌体提供选择性的通透屏障,能够阻止有害物质的渗透,允许营养物质进入菌体内,从而保持细菌正常生长。图4b显示,E. coli内部呈现均一分布的微观结构,细菌内浆质分布均匀,填充着蛋白质和DNA分子。与CSZ涂层作用后的E. coli细胞壁表面变得不平整,细胞壁部分溶解(图4c),说明细菌受外界有害物质影响。此外,CSZ涂层表面培养后的细菌内部形貌发生明显的变化,部分细菌内部浆质颜色由深变浅且分布不均匀,菌体内有中心光亮区域出现。在该光亮区域中,可观察到深色的紧密浓缩的物质,呈线性状态,如图d所示。据文献报道,该物质是处于压缩状态的DNA分子。DNA分子贮存细胞最重要的基因信息,任何对DNA分子的损伤都可能导致微生物变异或者死亡。当细菌遭受外来有害物质伤害时,菌体内部会形成低分子重量的区域,即4d中所示的中心光亮区域。该现象的形成是细菌抵抗外来有害物质的一种防御体制。DNA分子在松弛状态下能够有效地进行复制,而呈压缩状态的DNA分子失去复制的能力,影响微生物的繁殖。




图4 E. coli在Ti-6Al-4V(a,b)和CSZ涂层表面培养24小时的TEM形貌
依据上述实验结果,含锌涂层抗菌机理(图5)可以归纳为,涂层缓慢释放的Zn2+离子因库伦吸引作用吸附于细菌细胞壁上,与细胞壁外膜发生一系列复杂的生物化学反应,造成细胞壁溶解和细胞膜损伤,接着渗入菌体内的Zn2+离子作用于DNA分子,使其失去复制能力,最终杀死细菌。








图5 锌掺杂硅酸钙涂层抗菌机制示意图

